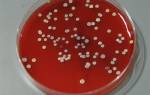

Выращивание бактерий в искусственных условиях положило начало целому направлению их изучения – исследованию бактериальных культур и их свойств. Оказалось, что существуют выраженные видовые различия в форме колоний и типе роста бактерий при их выращивании на плотной и жидкой питательной среде. Микробиология, начавшаяся в момент, когда интересные для исследователя бактерии стало возможно вырастить in vitro (то есть в стекле), до сих пор плотно изучает культуральные свойства бактерий – их особенности при выращивании в лабораторных условиях.
Бактерии и их свойства: описание видов и штаммов
Описывая разновидности бактерий, ученые указывают их морфологические, биохимические, культуральные и серологические свойства.
- Морфология бактериальных клеток изучается при исследовании мазков или висячих капель под микроскопом. Она обычно не позволяет однозначно идентифицировать вид бактерий, только их морфологические признаки – размер, окраску по Граму, наличие капсулы, спор, ворсинок и жгутиков, геометрическую форму. В зависимости от того, какие свойства описывает морфология, она может быть микро- или макро-морфологией. Первая занимается описанием клеток, вторая – описанием внешнего вида колоний.
- Культуральные свойства. К культуральным свойствам относятся внешний вид и форма колоний (это называется морфологией колоний), способ роста на плотной и жидкой питательной среде, требования к ее составу, характеризующие потребность бактериальных колоний в субстратах и витаминах, аэробных или анаэробных условиях.
- Биохимические свойства бактерий. Это ферментативные особенности (способность превращать одни вещества в другие при помощи характерных для данного представителя ферментов), а также их состав с точки зрения присутствия уникальных для конкретного вида или группы веществ.
- Серологические свойства. Изучение их позволяет поставить окончательную точку в определении видовой и штаммовой принадлежности колонии. Применяемые для серологической идентификации методы позволяют обнаружить характерные поверхностные антигены и по ним классифицировать бактериальную культуру.
Изучение культуральных свойств бактерий является важным аспектом микробиологии, и врачи подчеркивают его значимость для диагностики и лечения инфекционных заболеваний. Процесс начинается с изоляции микроорганизмов из образцов, таких как кровь, моча или ткани. Врачи отмечают, что выбор подходящей питательной среды критически важен, так как разные бактерии требуют специфических условий для роста.
После инокуляции среды наблюдается за ростом колоний, что позволяет определить морфологические и биохимические характеристики бактерий. Врачи акцентируют внимание на том, что культуральные исследования помогают не только идентифицировать патогены, но и оценить их чувствительность к антибиотикам. Это, в свою очередь, способствует выбору оптимальной терапии и предотвращению антибиотикорезистентности. Таким образом, культуральные свойства бактерий играют ключевую роль в клинической практике и обеспечивают эффективное лечение пациентов.

Культуральные характеристики
Культуральную характеристику роста бактериальных колоний на питательной среде дают после их визуального осмотра. Они могут иметь массу морфологических и культуральных различий, кроме того, способны меняться с течением времени. Молодые и старые колонии бактерий всегда описывают по культуральным свойствам отдельно:
- Форма. Бактериальные колонии по этой культуральной характеристике могут быть плоскими, округлыми, ризоидными (напоминать переплетение корней) или гирозными, напоминающими по форме головной мозг, иметь ровные, хорошо очерченные или рваные края.
- Размер. Важная характеристика морфологии колоний. Различают мелкие колонии диаметром 1-3 мм, средние размером от 2 до 4 мм и крупные, размер которых составляет 4 мм и более.
- Пропускание света. Бывают просвечивающие, или прозрачные, и непрозрачные бактериальные колонии.
- Поверхность. Может быть шероховатой или гладкой, морщинистой, блестящей, влажной, тусклой, слизистой или сухой.
- Структура. При изучении под микроскопом можно увидеть колонии различной морфологии – однородные, нитевидные или зернистые. Методы определения – микроскопия или исследование при помощи лупы.
- Цвет. Эта культуральная характеристика выявляется при наличии в бактериальных клетках пигментов. Цвет колоний иногда является видовым признаком и входит в название. Например, золотистый стафилококк, цианобактерии, пурпурные бактерии, синегнойная палочка и другие получили свои названия из-за характерной окраски их колоний, выращенных на питательной среде. Иногда пигменты бактерий выделяются в субстрат и окрашивают ее.
- Консистенция. Определяется при непосредственном контакте с колонией специального инструмента. Различают слизистые, мягкие, плотные и врастающие в агар.
- Профиль колонии может быть выпуклым или плоским, кратерообразным или конусовидным.
- Степень погружения в среду. Большинство колоний живут на поверхности субстрата. Однако существуют также глубинные, в виде чечевичек, погруженных в толщу среды, и донные бактерии, образующие пленки на дне сосудов с питательной средой.
- Люминесценция. Известны также несколько видов аэробных бактерий, способные к фосфоресценции (люминесценции). Их колонии способны до суток светиться желтоватым или зеленоватым цветом. Фотобактерии – жители различных водоемов, встречаются на чешуе и мясе рыбы. Их морфология может быть различной – среди светящихся видов встречаются кокки, вибрионы, палочки.
- В жидком субстрате морфология бактериальных колоний характеризуется образованием равномерной мути, пленки или осадка. В полужидких при посеве уколами подвижные бактерии вызывают помутнение в толще среды вокруг места посева, а неподвижные – только в самом месте укола. Некоторые бактерии в аэробных и анаэробных условиях выделяют различные газы (индол, скатол, меркаптан, сероводород, масляная кислота, диэтиловый эфир и тому подобное).
Изучение культуральных свойств бактерий вызывает большой интерес как у ученых, так и у студентов. Многие отмечают, что этот процесс требует не только теоретических знаний, но и практических навыков. В лабораториях используются различные среды для культивирования, что позволяет выявить особенности роста и метаболизма микроорганизмов. Исследователи подчеркивают важность контроля условий, таких как температура и pH, поскольку они существенно влияют на результаты. Некоторые специалисты делятся опытом работы с редкими штаммами, которые требуют особого подхода. В целом, изучение культуральных свойств бактерий открывает новые горизонты в микробиологии и биотехнологии, позволяя находить решения для многих медицинских и экологических проблем.
Виды сред для выращивания бактерий
Методы выращивания бактерий с целью выявления их культуральных свойств часто требуют применения субстратов различной плотности. Различают жидкие, полужидкие и плотные питательные среды:
- Жидкие. Готовятся на основе растворов или гидролизатов.
- Полужидкие. Требуют обязательного добавления веществ-уплотнителей в относительно небольшой концентрации. Так, агар-агар (малайское желе) в них добавляют в концентрации от 0,3 до 0,7%.
- Плотные. Содержат большое количество веществ-уплотнителей. Чаще всего это агар-агар в концентрации от 1,5 до 3%, реже – желатин в концентрации от 10 до 20%. Последний уплотнитель применяется относительно редко, так как плавится при температуре гораздо меньшей чем нормальная температура культивирования.
В зависимости от состава их делят на среды с определенным составом или синтетические, приготовленные в промышленных или лабораторных условиях из известных компонентов и те, состав которых не может быть определен точно – это растительные и животные природные субстраты (например, картофель, морковь, молоко или экстракты, полученные из них).
С точки зрения целей использования различают общие (общеупотребительные), селективные, обогащенные, специальные и дифференциально-диагностические среды:
- Общие. Применяются для культивирования неприхотливых культур. Это например, мясная вода, перевар Хоттингера или мясо-пептонный бульон, гидролизаты кормовых дрожжей или кильки и плотные среды, полученные при добавлении к данным бульонам агара.
- Обогащенные. Содержат добавки – кровь, ее сыворотку, специально подобранные углеводы.
- Специальные. Подобранные по составу для конкретного вида бактерий. Например, для возбудителя туляремии используется среда Мак-Коя с добавлением специально подготовленных яиц, а для лептоспир – среда Терских на основе фосфатов.
- Селективные (еще их называют элективными) – предназначены для отбора из смешанной популяции бактерий одного вида. Такие субстраты могут содержать компоненты, усиливающие рост искомого микроорганизма либо подавляющие рост остальной микрофлоры. Например, молочно-солевой агар, предназначенный для отбора стафилококков или среды Шустова, Раппопорт и Мюллера для выращивания сальмонелл.
- Дифференциально-диагностические позволяют определять наличие различных ферментов у бактерий. Могут быть различной консистенции. Наиболее известны среды Гисса, Левина, Эндо, содержащие различные субстраты для бактериальных ферментов – лактозу, галактозу, тиосульфат натрия и цветные индикаторы.
Методы культивирования аэробных и анаэробных бактерий с целью изучения их культуральных свойств существенно различаются между собой. Для аэробных бактерий применяются термостаты, шюттель-аппараты, колбы, бутыли и реакторы. Для анаэробных используются высокие концентрации веществ, повышающих восстановительный потенциал среды, и специальные жидкие или газовые среды. В качестве специального оборудования используются анаэростаты.
Кипячение субстратов позволяет удалить из них кислород. Часто применяется метод выращивания анаэробов в толще питательных сред, что необходимо для выявления культуральных свойств бактерий.

Вопрос-ответ
Что такое культуральная характеристика бактерий?
В нём подробно описывается, как отдельная бактериальная клетка со временем делится и образует колонию. Внешний вид колоний может различаться у разных видов бактерий и включать такие характеристики, как форма, цвет, текстура и характер роста.

Каким методом выделяют чистую культуру бактерий?
Для выделения чистых культур многих бактерий используют МПА, для дрожжей — сусло-агар. Недостатком этого метода является то, что иногда получаются не чистые, а смешанные культуры. Это является результатом того, что колонии могут образоваться не из одной, а из двух или нескольких клеток, попавших в одну точку.
Как наука изучает бактерии?
Микробиология — это дисциплина, изучающая строение, функции, генетическую структуру, экологию, эволюцию, влияние этих микроорганизмов на заболевания и взаимодействие этих микроорганизмов с человеком, другими организмами и окружающей средой.
Советы
СОВЕТ №1
Изучайте основные методы культивирования бактерий, такие как агаровые и жидкие среды. Понимание этих методов поможет вам лучше ориентироваться в процессе изучения культуральных свойств и их влияния на рост и развитие микроорганизмов.
СОВЕТ №2
Обратите внимание на условия, в которых проводятся эксперименты, такие как температура, pH и наличие кислорода. Эти факторы могут значительно влиять на культуральные свойства бактерий и их поведение в различных средах.
СОВЕТ №3
Регулярно проводите контрольные эксперименты для проверки полученных результатов. Это поможет вам убедиться в достоверности данных и выявить возможные ошибки в процессе изучения культуральных свойств.
СОВЕТ №4
Не забывайте о важности документации. Записывайте все наблюдения и результаты экспериментов, чтобы в дальнейшем можно было проанализировать данные и сделать выводы о культуральных свойствах изучаемых бактерий.